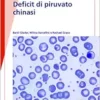
Deficit Di Piruvato Chinasi (Fast Facts) (Italian Edition) (PDF)

By Bertil Glader, Wilma Barcellini, Rachael Grace Lei potrebbe avere scarsa familiarità con il deficit di piruvato chinasi (PK). Si tratta di un raro difetto enzimatico ereditario che interessa la via glicolitica utilizzata dai globuli rossi per generare energia e che si manifesta come anemia emolitica. I sintomi variano notevolmente da un individuo all’altro, rendendo difficile la diagnosi, e le cure sono essenzialmente di supporto. Redatto da esperti nel settore, Fast Deficit di piruvato chinasi fornisce un’introduzione completa alla malattia, tra cui informazioni dettagliate difetto sottostante modalità di trasmissione ereditaria e relazione tra genotipo e fenotipo modalità di manifestazione della malattia elementi diagnostici fondamentali e metodi di differenziazione del deficit di PK da un gruppo eterogeneo di malattie emolitiche monitoraggio e gestione delle eventuali complicanze. Fast Deficit di piruvato chinasi susciterà l’interesse di medici curanti, ematologi, oncologi, pediatri, specialisti in medicina interna, infermieri del reparto di ematologia e studenti di in realtà di tutto coloro che desiderano approfondire la propria conoscenza di questa rara malattia genetica del sangue.
Product Details
Publisher : S Karger Ag; 1st edition (August 7, 2019)
Language : Italian
Paperback : 64 pages
ISBN-10 : 191277688X
ISBN-13 : 978-1912776887

Reviews
There are no reviews yet.